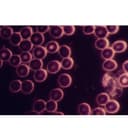
Thumbnail 11

🔬 Elevate your research game with crystal-clear precision and unstoppable zoom power!
The OMAX 40X-2000X Compound Advance Darkfield Trinocular LED Microscope combines a powerful magnification range with advanced optical technology, including achromatic objectives and dual brightfield/darkfield condensers. Its ergonomic design features a 360° swiveling trinocular head and adjustable interpupillary distance, making it ideal for professional research, clinical examination, and teaching. Equipped with a variable intensity 3W LED illumination system and built with durable metal components, this microscope ensures high-resolution imaging and reliable performance, all backed by a 5-year warranty.
| ASIN | B00FG8BBFO |
| Date First Available | September 26, 2013 |
| Is Discontinued By Manufacturer | No |
| Item Weight | 14 pounds |
| Item model number | M837SL-A191BOIL |
| Manufacturer | OMAX |
| Product Dimensions | 7.87 x 10.24 x 16.14 inches |
ترست بايلوت
منذ 3 أيام
منذ 5 أيام